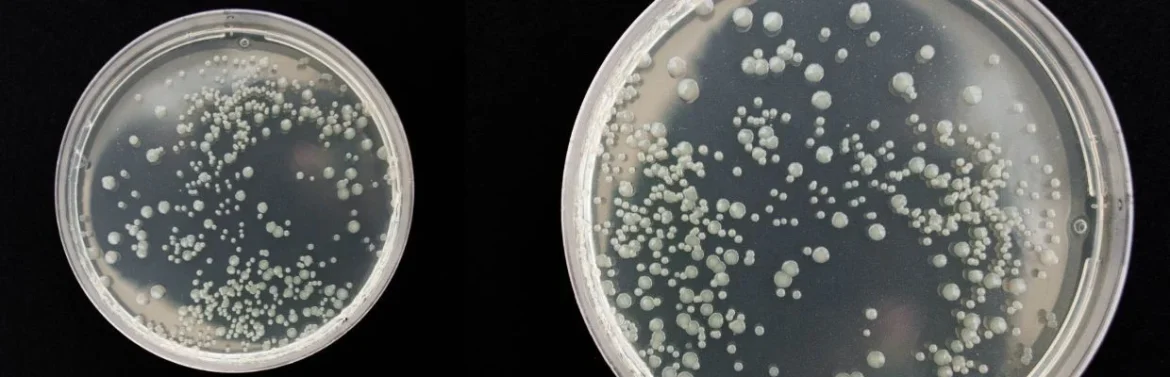

Çfarë duhet të dini për infeksionin me Listeria
- Listerioza është një infeksion bakterial serioz i shkaktuar nga konsumimi i ushqimeve të kontaminuara me Listeria monocytogenes.
- Bakteria është e pazakontë sepse mund të mbijetojë dhe të shumzohet edhe në temperatura të ulëta, si në frigorifer.
- Simptomat mund të variojnë nga forma të lehta, të ngjashme me gripin, deri në komplikacione të rënda si meningjiti ose septicemia.
- Grupet me rrezik më të lartë janë gratë shtatzëna, të porsalindurit, të moshuarit dhe personat me sistem imunitar të dobësuar.
- Parandalimi përmes higjienës së ushqimit është mënyra më efektive për t’u mbrojtur.
Çfarë është Listeria dhe si mund të infektoheni?
Listeria monocytogenes është një bakter shumë rezistent që mund të mbijetojë në kushte ku shumica e mikroorganizmave të tjerë nuk jetojnë. Ndryshe nga bakteret e zakonshme që shkaktojnë helmime ushqimore, Listeria mund të shumzohet edhe në temperatura rreth 4°C, pra në frigorifer.
Mënyrat kryesore të infektimit përfshijnë:
Ushqime të papërpunuara:
- Qumësht i papasterizuar
- Djathëra të butë (si feta, brie ose camembert) të prodhuar nga qumështi i papasterizuar
Produkte mishi të përpunuar:
- Suxhukë, pate ose hot-dog që nuk janë ngrohur mirë para konsumimit
Perime dhe fruta:
- Nëse janë rritur në tokë të kontaminuar ose janë larë me ujë të ndotur
Kontaminimi i kryqëzuar:
- Përdorimi i të njëjtit thikë ose dërrasë prerëse për mish të gjallë dhe ushqime që konsumohen pa gatim
Kush është më i rrezikuar?
Edhe personat e shëndetshëm mund të infektohen, por zakonisht zhvillojnë forma të lehta të sëmundjes. Megjithatë, për disa kategori infeksioni mund të jetë shumë i rrezikshëm:
- Gratë shtatzëna
- Të porsalindurit
- Personat mbi 65 vjeç
- Personat me sistem imunitar të dobësuar (sëmundje kronike, trajtime imunosupresive)
Simptomat e listeriozës: si ta dalloni infeksionin
Simptomat mund të shfaqen disa ditë pas konsumimit të ushqimit të kontaminuar, por periudha e inkubacionit mund të zgjasë deri në 70 ditë.
Forma e lehtë (gastrointestinale)
Kur infeksioni mbetet në sistemin tretës, simptomat janë të ngjashme me një gastroenterit:
- Nauze dhe të vjella
- Dhimbje barku dhe diarre
- Temperaturë e lehtë
- Dhimbje muskujsh
Forma e rëndë (invazive)
Kur bakteria përhapet në gjak ose në sistemin nervor:
- Dhimbje koke të forta
- Ngurtësi në qafë
- Konfuzion ose përgjumje
- Humbje ekuilibri
- Konvulsione
Si mund ta parandaloni listeriozën
Parandalimi është mënyra më e sigurt për të shmangur komplikacionet, sepse Listeria nuk ndryshon pamjen ose erën e ushqimit.
Masat kryesore të sigurisë:
Gatimi i mirë i ushqimit
- Mishi duhet të gatuhet në temperatura mbi 70°C, sepse bakteria shkatërrohet nga nxehtësia.
Shmangia e produkteve të rrezikshme
- Konsumoni vetëm qumësht të pasterizuar.
- Shmangni djathërat e butë nëse nuk jeni të sigurt për pasterizimin.
Larja e mirë e ushqimeve
- Lani mirë frutat dhe perimet nën ujë të rrjedhshëm, edhe nëse do t’i qëroni.
Pastërtia e frigoriferit
- Pastroni dhe dezinfektoni rregullisht raftet e frigoriferit.
Ndarja e ushqimeve
- Mos vendosni mish të gjallë pranë ushqimeve gati për konsum.
Kur duhet të shkoni urgjentisht te mjeku
Listerioza mund të kalojë shpejt nga simptoma të lehta në një urgjencë mjekësore, sidomos tek personat në rrezik.
Kërkoni ndihmë mjekësore urgjente nëse shfaqen:
- Temperaturë mbi 39°C me të dridhura
- Ngurtësi në qafë
- Dhimbje koke shumë të forta
- Konfuzion ose dezorientim
- Konvulsione
- Humbje ekuilibri
- Ndjeshmëri ndaj dritës me të vjella
Tek gratë shtatzëna, çdo temperaturë e pashpjegueshme duhet raportuar menjëherë te mjeku, edhe nëse simptomat janë të lehta.
Diagnostikimi dhe trajtimi i listeriozës
Diagnoza konfirmohet me analiza laboratorike, zakonisht:
- Analiza gjaku
- Analiza e lëngut cerebrospinal (në rast dyshimi për meningjit)
Trajtimi përfshin:
Antibiotikë
- Trajtimi kryesor bëhet me antibiotikë sipas rekomandimit të mjekut.
Hidratim
- I rëndësishëm në rast diarreje dhe të vjellash.
Shtrim në spital
- Nevojitet për rastet e rënda ose për pacientët në grupet e rrezikut.
Çfarë të bëni pasi të lexoni këtë artikull
- Kontrolloni nëse produktet e qumështit në frigorifer janë të pasterizuara.
- Nëse jeni shtatzënë dhe keni temperaturë pas konsumimit të ushqimeve të rrezikshme, kontaktoni menjëherë mjekun.
- Pastroni dhe dezinfektoni frigoriferin.
- Përdorni termometër kuzhine për të kontrolluar temperaturën e mishit.
- Lani duart me sapun për të paktën 20 sekonda pas manipulimit të mishit të gjallë.
Pyetje të shpeshta
A mund të jetojë Listeria në frigorifer?
Po. Ajo mund të shumzohet edhe në temperatura të ulëta.
A është e rrezikshme për personat e shëndetshëm?
Zakonisht shkakton forma të lehta, por mund të jetë serioze për personat në rrezik.
Si shkatërrohet Listeria?
Përmes gatimit në temperatura të larta (mbi 70°C) dhe higjienës së mirë ushqimore.